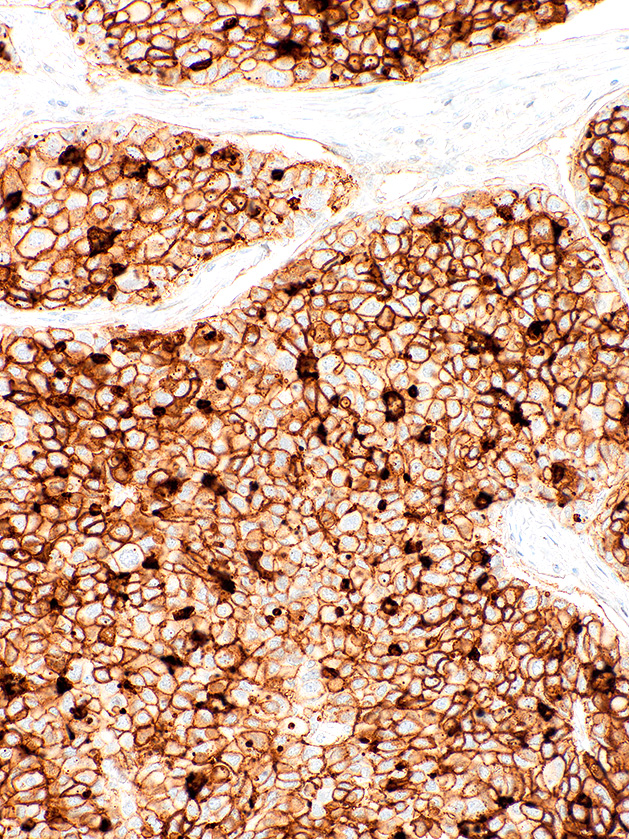

[Genomeme] CD73
CAT. NO. IHC073-100
CLONE:
IHC073
ISOTYPE:
IgG1, Kappa
HOST SPECIES:
Mouse
CLONALITY:
Monoclonal
POSITIVE CONTROL:
Placenta, Tonsil
DILUTION RANGE:
INTENDED USE/REG. STATUS:
CE-IVD
Cluster of Differentiation 73 (CD73), also known as Ecto-5'-Nucleotidase (ecto-5'-NT), is a cell surface enzyme found in most tissues. CD73 catalyzes the breakdown of AMP to adenosine, thereby modulating inflammatory and T-cell responses. Reports have implicated CD73 expression in tumour progression and carcinogenesis, as CD73 is a key regulatory molecule in the proliferation, migration, and invasion of cancer cells in vitro, as well as tumour angiogenesis and tumour immune escape in vivo. Due to this key involvement in cancer, CD73 has become an appealing target for cancer immunotherapy. CD73 expression has also been linked to favourable prognosis in breast carcinoma.
휴바이오랩 (Hubiolab)
hubiolab@gmail.com
010-9468-7169
Hubiolab(휴바이오랩)
컨설팅 원하는 제품 군을 찾지만 시간이 맞지 않거나, 소요되는 제품이 맞지 않으면, 적절한 제품을 찾아서 최대한 진행을 도와 드립니다. Get Started
www.hubiolab.com
'Genomeme' 카테고리의 다른 글
| [Genomeme] HER2/neu (0) | 2022.08.18 |
|---|---|
| [Genomeme] Fibronectin (0) | 2022.06.24 |
| [Genomeme] EGFR (0) | 2022.06.02 |
| [Genomeme] CD63 (0) | 2022.02.15 |
| [Genomeme] BRAF V600E (0) | 2022.01.24 |